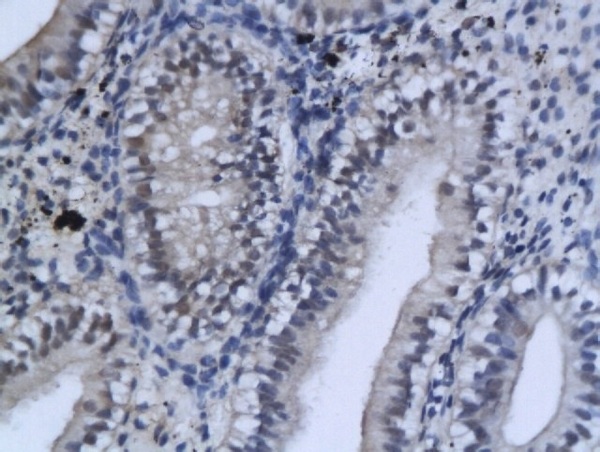

Image provided by One World Lab validation program. A549 cells probed with Rabbit Anti-GSK-3 Beta Polyclonal Antibody (bs-0028R) at 1:50 for 60 minutes at room temperature followed by Goat Anti-Rabbit IgG (H+L) Alexa Fluor 488 Conjugated secondary antibody.
GSK-3 Beta Polyclonal Antibody
BS-0028R
ApplicationsFlow Cytometry, ImmunoFluorescence, Western Blot, ELISA, ImmunoCytoChemistry, ImmunoHistoChemistry, ImmunoHistoChemistry Frozen, ImmunoHistoChemistry Paraffin
Product group Antibodies
ReactivityHuman, Mouse, Rat
TargetGSK3B
Overview
- SupplierBioss
- Product NameGSK-3 Beta Polyclonal Antibody
- Delivery Days Customer16
- ApplicationsFlow Cytometry, ImmunoFluorescence, Western Blot, ELISA, ImmunoCytoChemistry, ImmunoHistoChemistry, ImmunoHistoChemistry Frozen, ImmunoHistoChemistry Paraffin
- Applications SupplierWB(1:300-5000), ELISA(1:500-1000), FCM(1:20-100), IHC-P(1:200-400), IHC-F(1:100-500), IF(IHC-P)(1:50-200), IF(IHC-F)(1:50-200), IF(ICC)(1:50-200)
- CertificationResearch Use Only
- ClonalityPolyclonal
- Concentration1 ug/ul
- ConjugateUnconjugated
- Gene ID2932
- Target nameGSK3B
- Target descriptionglycogen synthase kinase 3 beta
- Target synonymsglycogen synthase kinase-3 beta, GSK-3 beta, serine/threonine-protein kinase GSK3B
- HostRabbit
- IsotypeIgG
- Protein IDP49841
- Protein NameGlycogen synthase kinase-3 beta
- ReactivityHuman, Mouse, Rat
- Storage Instruction-20°C
- UNSPSC12352203
References
- Zhou X, Cai G, Mao S, et al. Modulating NMDA receptors to treat MK-801-induced schizophrenic cognition deficit: effects of clozapine combining with PQQ treatment and possible mechanisms of action. BMC Psychiatry. 2020,20(1):106. doi: 10.1186/s12888-020-02509-zRead this paper
- Pan J, Fang S, Tian H, et al. lncRNA JPX/miR-33a-5p/Twist1 axis regulates tumorigenesis and metastasis of lung cancer by activating Wnt/β-catenin signaling. Mol Cancer. 2020,19(1):9. doi: 10.1186/s12943-020-1133-9Read this paper
- Sun L, Li Z, Xue H, et al. MiR-26a promotes fracture healing of nonunion rats possibly by targeting SOSTDC1 and further activating Wnt/β-catenin signaling pathway. Mol Cell Biochem. 2019,460(1-2):165-173. doi: 10.1007/s11010-019-03578-9Read this paper
- Ma W, Li X, Song P, et al. A vanillin derivative suppresses the growth of HT29 cells through the Wnt/β-catenin signaling pathway. Eur J Pharmacol. 2019,849:43-49. doi: 10.1016/j.ejphar.2019.01.047Read this paper
- Yuan C, Guo X, Zhou Q, et al. OAB-14, a bexarotene derivative, improves Alzheimer's disease-related pathologies and cognitive impairments by increasing β-amyloid clearance in APP/PS1 mice. Biochim Biophys Acta Mol Basis Dis. 2019,1865(1):161-180. doi: 10.1016/j.bbadis.2018.10.028Read this paper
- Zhang YQ, Wei XL, Liang YK, et al. Over-Expressed Twist Associates with Markers of Epithelial Mesenchymal Transition and Predicts Poor Prognosis in Breast Cancers via ERK and Akt Activation. PLoS One. 2015,10(8):e0135851. doi: 10.1371/journal.pone.0135851Read this paper
- Freese C, Reinhardt S, Hefner G, et al. A novel blood-brain barrier co-culture system for drug targeting of Alzheimer's disease: establishment by using acitretin as a model drug. PLoS One. 2014,9(3):e91003. doi: 10.1371/journal.pone.0091003Read this paper